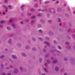

1. Patients with co-occurring substance use disorder and depression were less likely to received guideline-concordant treatment for depression, both in terms of pharmacology and psychotherapy, when compared with patients with depression alone.
Evidence Level Rating: 2 (Good)
It is not uncommon to find depression and substance use disorders (SUD) co-occurring, and the combination of the two leads to poorer outcomes. As such, treatment of depression is a priority for patients with SUD. However, to date there is no data examining whether patients with co-occurring SUD and depression receive similar care to those without SUD for both pharmacological- and psychotherapy-based treatment modalities. This retrospective cohort study involved veterans receiving care through the U.S. Veterans Health Administration, including 53,034 patients diagnosed with a new episode of depression, of whom 28,081 received antidepressant treatment and 18,484 received psychotherapy. In this particular cohort, 7,516 patients had a diagnosed SUD in the year prior to their diagnosis of depression. It was found that, despite having more contact with the health care system on average, patients with SUD received less guideline-concordant depression treatment across all metrics. Indeed, with regards to pharmacotherapy, acute- and continuous-phase antidepressant treatment was provided to 59.4% and 36.3%, respectively, of patients with co-occurring depression and SUD. In contrast, 66.2% and 44.8% of patients without SUD received acute- and continuous-phase antidepressant treatment. This same pattern was observed among patients receiving psychotherapy; 31.6% and 26.8% of those with SUD received acute and continuation phases of depression treatment, respectively, compared with 35.4% and 32.2% of those without SUD. Furthermore, it was found that among specific SUDs, patients with alcohol, opioid, and cannabis use disorders were more likely to receive lower-quality depression care in the acute phase. In all, this study involving a large cohort from the nation’s largest provider of health care indicates a treatment gap among those with co-occurring SUD and depression. More research needs to be done to identify strategies to deploy more equitable and effective treatment plans for patients with both SUD and depression.
Click to read the study in the American Journal of Psychiatry
Image: PD
©2020 2 Minute Medicine, Inc. All rights reserved. No works may be reproduced without expressed written consent from 2 Minute Medicine, Inc. Inquire about licensing here. No article should be construed as medical advice and is not intended as such by the authors or by 2 Minute Medicine, Inc.